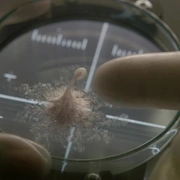

剧情简介
大卫(杰克·吉伦哈尔 Jake Gyllenhaal 饰)、米兰达(丽贝卡·弗格森 Rebecca Ferguson 饰)、罗里(瑞安·雷诺兹 Ryan Reynolds 饰)、秀(真田广之 饰)和休(阿利安·巴克瑞 Ariyon Bakare 饰)是在同一艘太空船上工作的宇航员们。一次偶然之中,他们在火星上发现了一个尚未成熟的生命体。休将这个生命体带回了实验室,让大家没有想到的是,这个小小的细胞在外界的刺激之下竟然开始了飞速的成长。 随着生命体的长大,事态的发展开始失去了控制,该生命体展现出了强大的攻击力和高超的智力,先后杀死了数名船员。不仅如此,大卫发现生命体似乎想随着飞船一起降落地球,而一旦它的阴谋得逞,地球上的人类势必将要面临灭顶之灾。